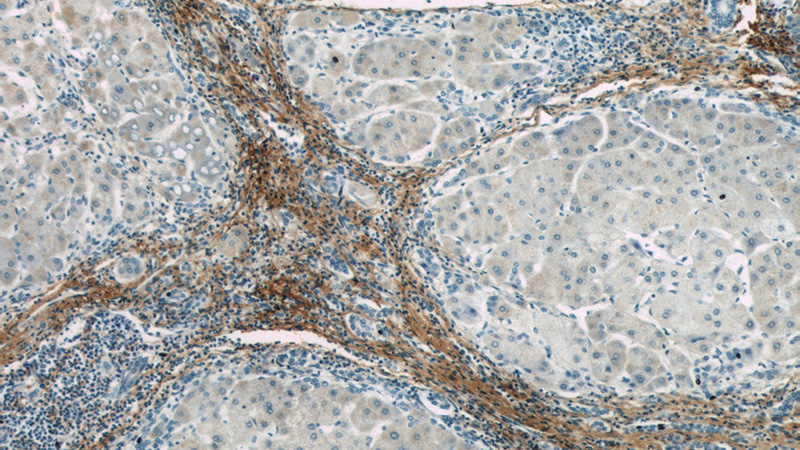
Immunohistochemistry of paraffin-embedded human hepatocirrhosis slide using Catalog No:107213(FMOD Antibody) at dilution of 1:50
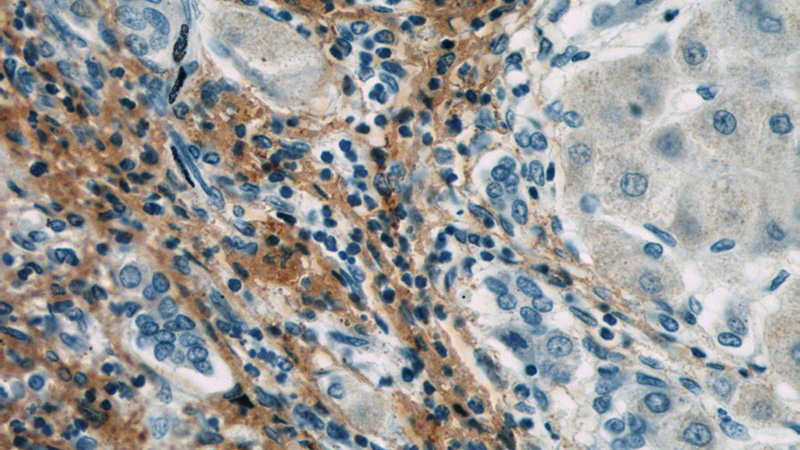
Immunohistochemistry of paraffin-embedded human hepatocirrhosis slide using Catalog No:107213(FMOD Antibody) at dilution of 1:50

-
Product Name
Fibromodulin antibody
- Documents
-
Description
Fibromodulin Mouse Monoclonal antibody. Positive WB detected in Human kidney, human kidney tissue, human stomach tissue. Positive IHC detected in human hepat℃irrhosis tissue. Observed molecular weight by Western-blot: 59 kDa
-
Tested applications
ELISA, WB, IHC
-
Species reactivity
Human; other species not tested.
-
Alternative names
fibromodulin antibody; FMOD antibody; KSPG fibromodulin antibody; SLRR2E antibody
-
Isotype
Mouse IgG1
-
Preparation
This antibody was obtained by immunization of Fibromodulin recombinant protein (Accession Number: NM_002023). Purification method: Caprylic acid/ammonium sulfate precipitation.
-
Clonality
Monoclonal
-
Formulation
PBS with 0.1% sodium azide and 50% glycerol pH 7.3.
-
Storage instructions
Store at -20℃. DO NOT ALIQUOT
-
Applications
Recommended Dilution:
WB: 1:200-1:2000
IHC: 1:20-1:200
-
Validations

human kidney tissue were subjected to SDS PAGE followed by western blot with Catalog No:107213(FMOD antibody) at dilution of 1:250
Immunohistochemistry of paraffin-embedded human hepatocirrhosis slide using Catalog No:107213(FMOD Antibody) at dilution of 1:50
Immunohistochemistry of paraffin-embedded human hepatocirrhosis slide using Catalog No:107213(FMOD Antibody) at dilution of 1:50
-
Background
Fibromodulin (FMOD), an extracellular matrix protein, belongs to the small leucine-rich proteoglycan family. Fibromodulin is a collagen-binding protein present in many types of connective tissues, e.g. cartilage, tendon, skin, sclera and cornea (PMID: 2531085). It is involved in fibrillogenesis, cell adhesion, and cytokine activity modulation (PMID: 15741214). Fibromodulin may participate in the assembly of the extracellular matrix as it interacts with type I and type II collagen fibrils and inhibits fibrillogenesis in vitro. It may also regulate TGF-beta activities by sequestering TGF-beta into the extracellular matrix. The calculated molecular mass of fibromodulin is 43 kDa, extracellular fibromodulin appears as one single band of 59 kDa due to glycosylation (PMID: 2531085; 22138190).
-
References
- Adini I, Ghosh K, Adini A. Melanocyte-secreted fibromodulin promotes an angiogenic microenvironment. The Journal of clinical investigation. 124(1):425-36. 2014.
- Adini I, Adini A, Bazinet L, Watnick RS, Bielenberg DR, D'Amato RJ. Melanocyte pigmentation inversely correlates with MCP-1 production and angiogenesis-inducing potential. FASEB journal : official publication of the Federation of American Societies for Experimental Biology. 29(2):662-70. 2015.
Related Products / Services
Please note: All products are "FOR RESEARCH USE ONLY AND ARE NOT INTENDED FOR DIAGNOSTIC OR THERAPEUTIC USE"
